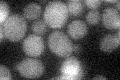
YOL100W
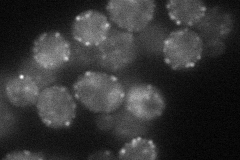
YOL100W
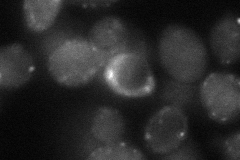
YOL100W

View description
Serine/threonine protein kinase involved in sphingolipid-mediated signaling pathway that controls endocytosis; activates Ypk1p and Ykr2p, components of signaling cascade required for maintenance of cell wall integrity; redundant with Pkh1p
Localization:
Intensity:
Fold change:
Significance:
-
C’ GFP library in SD
below threshold19.36 -
N' NOP1pr-GFP in SD
punctate48.1748 -
N' TEF2pr-mCherry in SD

cell periphery,punctate34.9821 -
N' NATIVEpr-GFP in SD

below threshold13.706 -
N' TEF2pr-VC and Cyto-VN in SD
cell periphery,punctate39.4433 -
C’ GFP library in SD+DTT

cytosol20.81.07No -
C’ GFP library in SD+H2O2

cytosol21.831.12No -
C’ GFP library in Starvation Media

cytosol22.521.16No -
C’ GFP library on the background of Pup2-DaMP

N/A -
C’ GFP library on the background of CCT mutant

N/A0N/AYes
